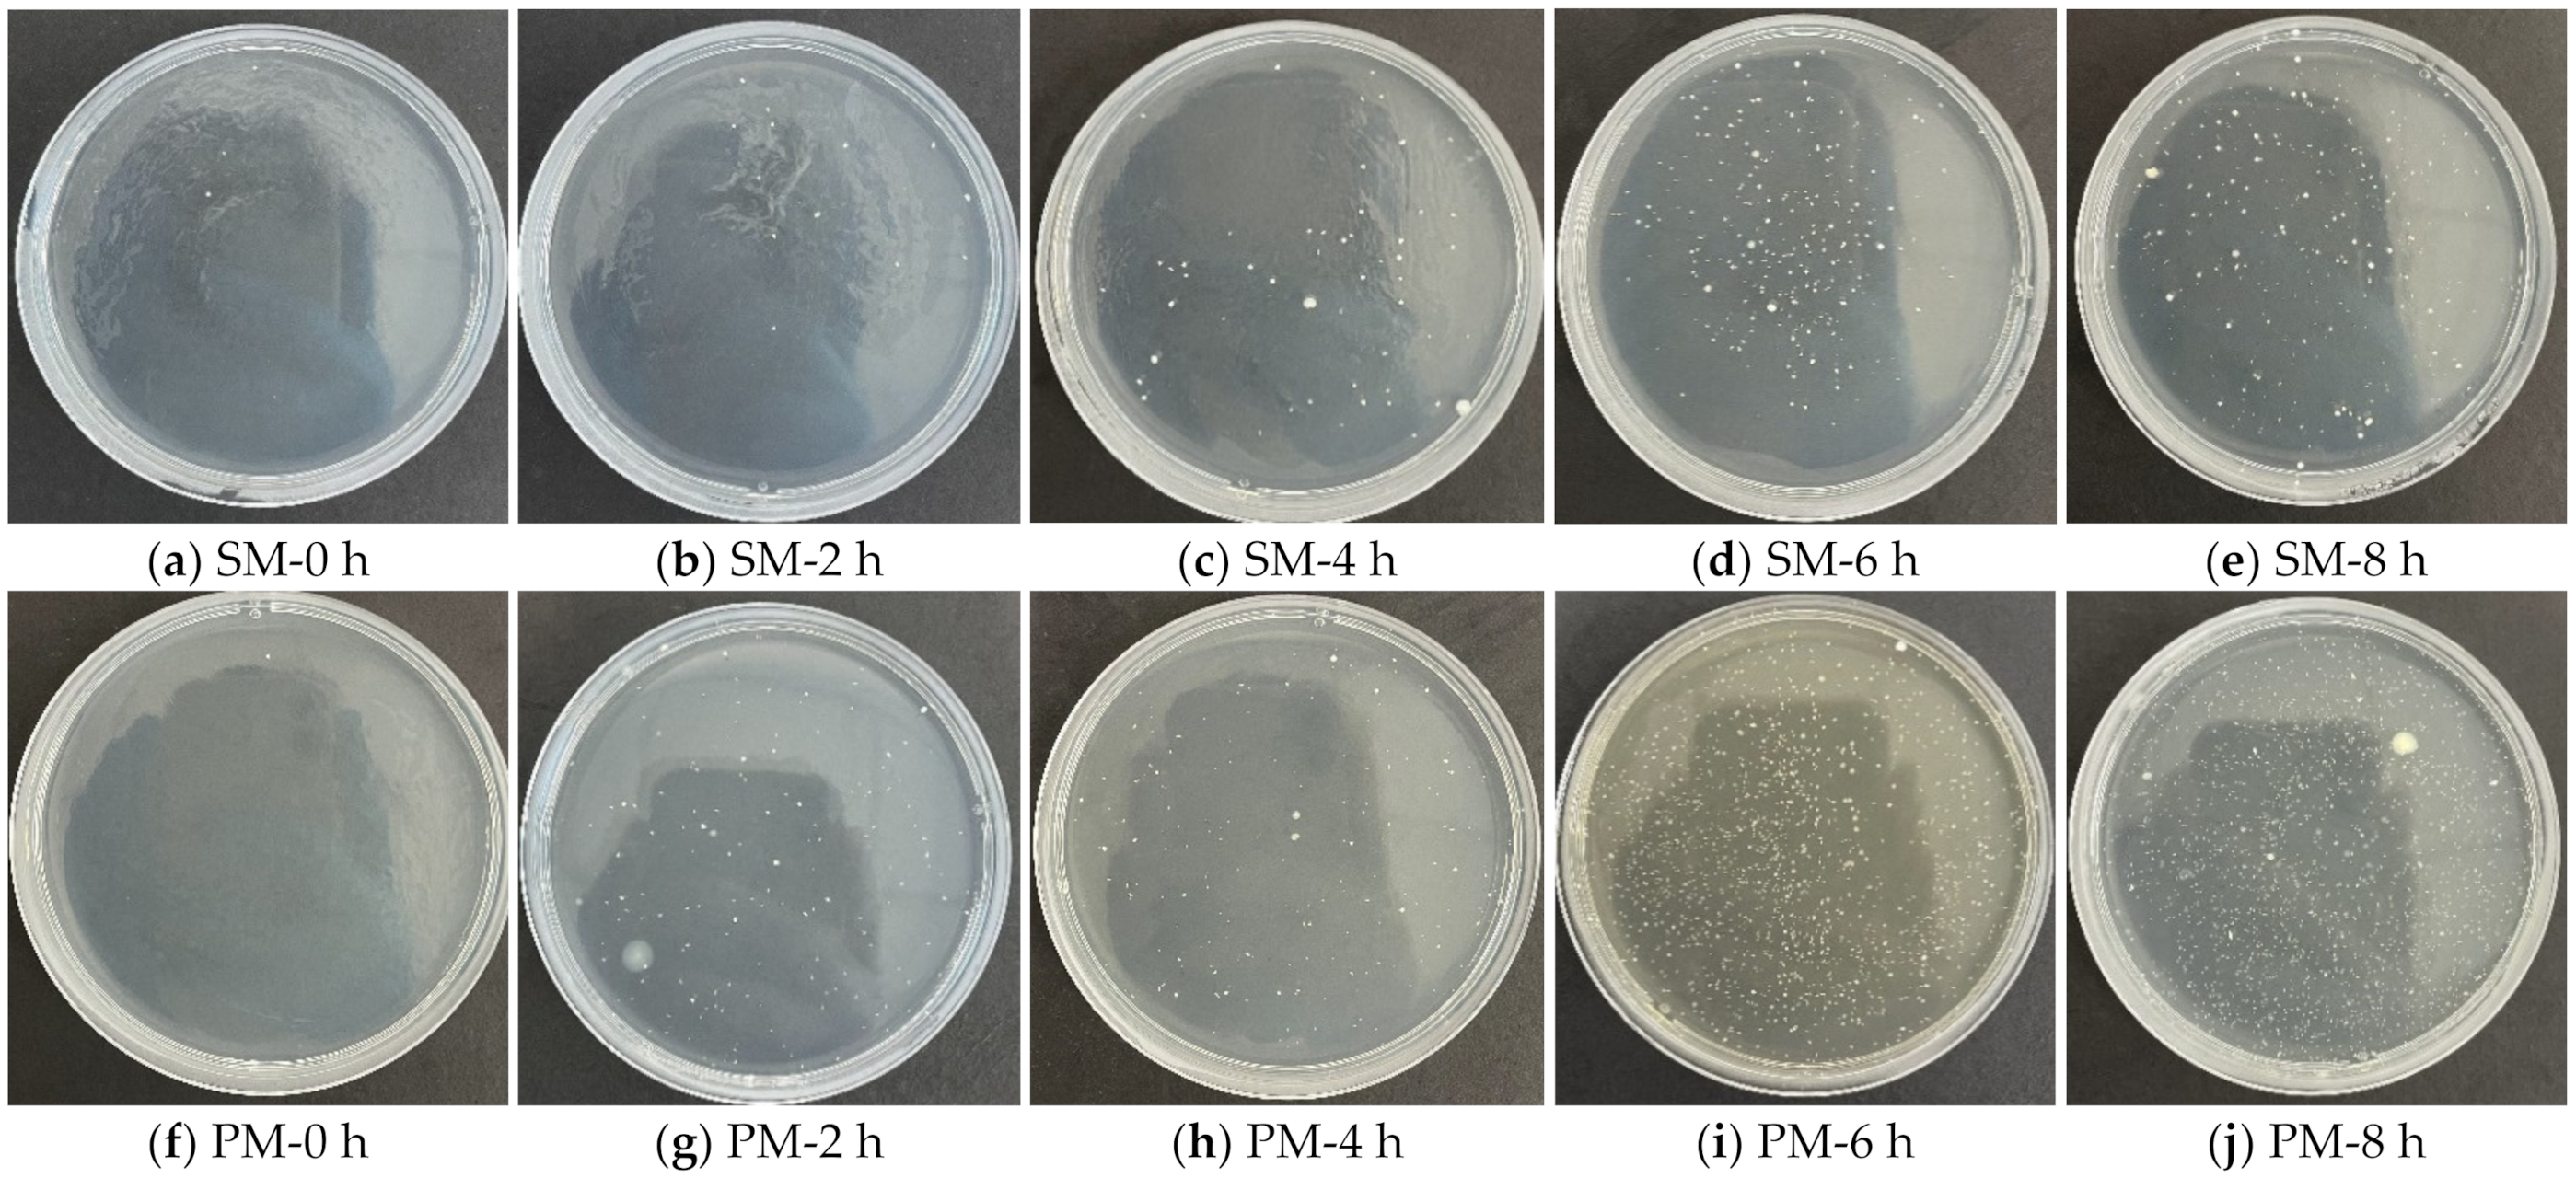

Prolonged Use of Surgical Masks and Respirators Affects the Protection and Comfort for Healthcare Workers
Abstract
1. Introduction
2. Materials and Methods
2.1. Experimental Sample
2.2. Test Method
2.2.1. Protective Properties
- Filtration efficiency
- Synthetic blood resistance of mask surface
- Total bacterial colony count
2.2.2. Comfort Properties
- Infrared imaging of facial skin temperature
- Respiratory system resistance
- Moisture permeability
2.2.3. Statistical Test
3. Results and Discussion
3.1. Filtration Efficiency
3.2. Synthetic Blood Resistance of Mask Surface
3.3. Total Bacterial Colonies
3.4. Breathing Resistance
3.5. Infrared Imaging of Facial Skin Temperature
3.6. Moisture Permeability of Mask
3.7. Optimal Wearing Time for Two Types of Masks
4. Conclusions
Author Contributions
Funding
Institutional Review Board Statement
Informed Consent Statement
Data Availability Statement
Acknowledgments
Conflicts of Interest
References
- Militky, J.; Novak, O.; Kremenakova, D.; Wiener, J.; Venkataraman, M.; Zhu, G.; Yao, J.; Aneja, A. A review of impact of textile research on protective face masks. Materials 2021, 14, 1937. [Google Scholar] [CrossRef] [PubMed]
- Anderson, R.M.; Heesterbeek, H.; Klinkenberg, D.; Hollingsworth, T.D. How will country-based mitigation measures influence the course of the COVID-19 epidemic? Lancet 2020, 395, 931–934. [Google Scholar] [CrossRef]
- Chen, J.; Wang, R.; Wang, M.; Wei, G.-W. Mutations strengthened SARS-CoV-2 infectivity. J. Mol. Biol. 2020, 432, 5212–5226. [Google Scholar] [CrossRef] [PubMed]
- Galloway, S.E.; Paul, P.; MacCannell, D.R.; Johansson, M.A.; Brooks, J.T.; MacNeil, A.; Slayton, R.B.; Tong, S.; Silk, B.J.; Armstrong, G.L.; et al. Emergence of SARS-CoV-2 B.1.1.7 lineage—United States, 29 December 2020–12 January 2021. MMWR Morb. Mortal. Wkly. Rep. 2021, 70, 95–99. [Google Scholar] [CrossRef]
- Li, J.Y.; You, Z.; Wang, Q.; Zhou, Z.J.; Qiu, Y.; Luo, R.; Ge, X.Y. The epidemic of 2019-novel-coronavirus (2019-NCoV) pneumonia and insights for emerging infectious diseases in the future. Microbes Infect. 2020, 22, 80–85. [Google Scholar] [CrossRef]
- Abobaker, A.; Alzwi, A. The eye: A possible new route of infection in COVID-19. Disaster Med. Public Health Prep. 2020, 14, E25–E26. [Google Scholar] [CrossRef]
- Nguyen, L.H.; Drew, D.A.; Graham, M.S.; Joshi, A.D.; Guo, C.-G.; Ma, W.; Mehta, R.S.; Warner, E.T.; Sikavi, D.R.; Lo, C.-H.; et al. Risk of COVID-19 among front-line health-care workers and the general community: A prospective cohort study. Lancet Public Health 2020, 5, e475–e483. [Google Scholar] [CrossRef]
- Liao, M.; Liu, H.; Wang, X.; Hu, X.; Huang, Y.; Liu, X.; Brenan, K.; Mecha, J.; Nirmalan, M.; Lu, J.R. A technical review of face mask wearing in preventing respiratory COVID-19 transmission. Curr. Opin. Colloid Interface Sci. 2021, 52, 101417. [Google Scholar] [CrossRef]
- O’Dowd, K.; Nair, K.M.; Forouzandeh, P.; Mathew, S.; Grant, J.; Moran, R.; Bartlett, J.; Bird, J.; Pillai, S.C. Face masks and respirators in the fight against the COVID-19 pandemic: A review of current materials, advances and future perspectives. Materials 2020, 13, 3363. [Google Scholar] [CrossRef]
- Li, X.; Ding, P.; Deng, F.; Mao, Y.; Zhou, L.; Ding, C.; Wang, Y.; Luo, Y.; Zhou, Y.; MacIntyre, C.R.; et al. Wearing time and respiratory volume affect the filtration efficiency of masks against aerosols at different sizes. Environ. Technol. Innov. 2022, 25, 102165. [Google Scholar] [CrossRef]
- Han, J.; Guan, X.; Lin, J.; Wang, L.; Lin, J.; Gao, X. Research on efficacy of masks under different simulated wearing modes. Chin. J. Nosocomiology 2022, 32, 1875–1879. [Google Scholar]
- Notice on Printing and Distributing Technical Guidelines for Novel Coronavirus Infection Prevention and Control in Medical Institutions. In Bulletin of the National Health Commission of the People’s Republic of China, 3rd ed.; National Health Commission: Beijing, China, 2021; Volume 9, pp. 5–18.
- Li, L.; Niu, M.; Zhu, Y. Assessing the effectiveness of using various face coverings to mitigate the transport of airborne particles produced by coughing indoors. Aerosol Sci. Technol. 2020, 55, 332–339. [Google Scholar] [CrossRef]
- Guidelines for the Use of Common Medical Protective Equipment in the Prevention and Control of Novel Coronavirus Pneumonia (Trial Implementation). Available online: http://www.nhc.gov.cn/yzygj/s7659/202001/e71c5de925a64eafbe1ce790debab5c6.shtml (accessed on 27 January 2021).
- World Health Organization. COVID-19: Occupational Health and Safety for Health Workers: Interim Guidance. Available online: https://www.who.int/publications/i/item/WHO-2019-nCoV-HCW_advice-2021-1 (accessed on 2 February 2021).
- Armand, Q.; Whyte, H.E.; Verhoeven, P.; Grattard, F.; Leclerc, L.; Curt, N.; Ragey, S.P.; Pourchez, J. Impact of Medical Face Mask Wear on Bacterial Filtration Efficiency and Breathability. Environ. Technol. Innov. 2022, 28, 102897. [Google Scholar] [CrossRef]
- Varanges, V.; Caglar, B.; Lebaupin, Y.; Batt, T.; He, W.; Wang, J.; Rossi, R.M.; Richner, G.; Delaloye, J.-R.; Michaud, V. On the Durability of Surgical Masks after Simulated Handling and Wear. Sci. Rep. 2022, 12, 4938. [Google Scholar] [CrossRef] [PubMed]
- Rebmann, T.; Carrico, R.; Wang, J. Physiologic and other effects and compliance with long-term respirator use among medical intensive care unit nurses. Am. J. Infect. Control. 2013, 41, 1218–1223. [Google Scholar] [CrossRef] [PubMed]
- Liu, C.; Li, G.; He, Y.; Zhang, Z.; Ding, Y. Effects of wearing masks on human health and comfort during the COVID-19 pandemic. IOP Conf. Ser. Earth Environ. Sci. 2020, 531, 012034. [Google Scholar] [CrossRef]
- Shechtman, L.; Ben-Haim, G.; Ben-Zvi, I.; Steel, L.; Ironi, A.; Huszti, E.; Chatterji, S.; Levy, L. Physiological Effects of Wearing N95 Respirator on Medical Staff During Prolong Work Hours in Covid-19 Departments. J. Occup. Environ. Med. 2022, 64, E378–E380. [Google Scholar] [CrossRef] [PubMed]
- Wangsan, K.; Sapbamrer, R.; Sirikul, W.; Panumasvivat, J.; Surawattanasakul, V.; Assavanopakun, P. Effect of N95 Respirator on Oxygen and Carbon Dioxide Physiologic Response: A Systematic Review and Meta-Analysis. Int. J. Environ. Res. Public Health 2022, 19, 8646. [Google Scholar] [CrossRef]
- Gupta, D. Living with in-mask micro-climate. Med. Hypotheses 2020, 144, 110010. [Google Scholar] [CrossRef]
- Martel, T.; Orgill, D.P. Medical device-related pressure injuries during the COVID-19 pandemic. J. Wound Ostomy Cont. Nurs. 2020, 47, 430–434. [Google Scholar] [CrossRef]
- Park, S.; Han, J.; Yeon, Y.M.; Kang, N.Y.; Kim, E. Effect of face mask on skin characteristics changes during the COVID-19 pandemic. Skin Res. Technol. 2021, 27, 554–559. [Google Scholar] [CrossRef] [PubMed]
- Gefen, A.; Ousey, K. Update to device related pressure ulcers: SECURE prevention. COVID-19 face masks and skin damage. J. Wound Care 2020, 29, 245–259. [Google Scholar] [CrossRef] [PubMed]
- Barnawi, G.M.; Barnawi, A.M.; Samarkandy, S. The association of the prolonged use of personal protective equipment and face mask during COVID-19 pandemic with various dermatologic disease manifestations: A systematic review. Cureus 2021, 13, e16544. [Google Scholar] [CrossRef] [PubMed]
- Montero-Vilchez, T.; Cuenca-Barrales, C.; Martinez-Lopez, A.; Molina-Leyva, A.; Arias-Santiago, S. Skin adverse events related to personal protective equipment: A systematic review and meta-analysis. J. Eur. Acad. Dermatol. Venereol. 2021, 35, 1994–2006. [Google Scholar] [CrossRef] [PubMed]
- Ong, J.J.Y.; Bharatendu, C.; Goh, Y.; Tang, J.Z.Y.; Sooi, K.W.X.; Tan, Y.L.; Tan, B.Y.Q.; Teoh, H.-L.; Ong, S.T.; Allen, D.M.; et al. Headaches associated with personal protective equipment—A cross-sectional study among frontline healthcare workers during COVID-19. Headache J. Head Face Pain 2020, 60, 864–877. [Google Scholar] [CrossRef]
- Lee, H.P.; Wang, D.Y. Objective assessment of increase in breathing resistance of N95 respirators on human subjects. Ann. Occup. Hyg. 2011, 55, 917–921. [Google Scholar] [CrossRef][Green Version]
- Tcharkhtchi, A.; Abbasnezhad, N.; Seydani, M.Z.; Zirak, N.; Farzaneh, S.; Shirinbayan, M. An Overview of Filtration Efficiency through the Masks: Mechanisms of the Aerosols Penetration. Bioact. Mater. 2021, 6, 106–122. [Google Scholar] [CrossRef]
- Zhu, N.; Zhang, D.; Wang, W.; Li, X.; Yang, B.; Song, J.; Zhao, X.; Huang, B.; Shi, W.; Lu, R.; et al. A novel coronavirus from patients with pneumonia in China, 2019. N. Engl. J. Med. 2020, 382, 727–733. [Google Scholar] [CrossRef]
- Stadnytskyi, V.; Bax, C.E.; Bax, A.; Anfinrud, P. The airborne lifetime of small speech droplets and their potential importance in SARS-CoV-2 transmission. Proc. Natl Acad. Sci. USA 2020, 117, 11875–11877. [Google Scholar] [CrossRef]
- Ogbuoji, E.A.; Zaky, A.M.; Escobar, I.C. Advanced research and development of face masks and respirators pre and post the coronavirus disease 2019 (COVID-19) pandemic: A critical review. Polymers 2021, 13, 1998. [Google Scholar] [CrossRef]
- Yovcheva, T.A.; Mekishev, G.A.; Marinov, A.T. A percolation theory analysis of surface potential decay related to corona charged polypropylene (PP) electrets. J. Phys. Condens. Matter. 2004, 16, 455–464. [Google Scholar] [CrossRef]
- Zhang, X.; Liu, J.; Zhang, H.; Wang, Y.; Jin, X. Preparation technology and research status of nonwoven filtration materials for individual protective masks. J. Text. Res. 2020, 41, 168–174. [Google Scholar] [CrossRef]
- Rengasamy, S.; Eimer, B.C. N95-companion measurement of cout/cin ratios for two N95 filtering facepiece respirators and one surgical mask. J. Occup. Environ. Hyg. 2013, 10, 527–532. [Google Scholar] [CrossRef] [PubMed]
- Seidi, F.; Deng, C.; Zhong, Y.; Liu, Y.; Huang, Y.; Li, C.; Xiao, H. Functionalized masks: Powerful materials against COVID-19 and future pandemics. Small 2021, 17, 2102453. [Google Scholar] [CrossRef] [PubMed]
- Guan, X.; Han, J.; Lin, J.; Wang, L.; Lin, J.; Gao, X. Research on anti-blood penetration performance of different types of masks. Chin. J. Infect. Control 2022, 21, 861–869. (In Chinese) [Google Scholar] [CrossRef]
- Park, A.-M.; Khadka, S.; Sato, F.; Omura, S.; Fujita, M.; Hashiwaki, K.; Tsunoda, I. Bacterial and fungal isolation from face masks under the COVID-19 pandemic. Sci. Rep. 2022, 12, 11361. [Google Scholar] [CrossRef]
- Johnson, B.D.; Aaron, E.A.; Babcock, M.A.; Dempsey, J.A. Respiratory muscle fatigue during exercise: Implications for performance. Med. Sci. Sports Exerc. 1996, 28, 1129–1137. [Google Scholar] [CrossRef]
- Madan, M.; Madan, K.; Mohan, A.; Hadda, V.; Tiwari, P.; Mittal, S. Personal protective equipment and particulate filter use during the COVID-19 pandemic: “acidotic times”. Arch. Bronconeumol. 2021, 57, 83. [Google Scholar] [CrossRef]
- Lim, E.; Seet, R.; Lee, K.H.; Wilder-Smith, E.P.V.; Chuah, B.; Ong, B. Headaches and the N95 face-mask amongst healthcare providers. Acta Neurol. Scand. 2010, 113, 199–202. [Google Scholar] [CrossRef]
- Qing, Y.E.; Xi, Y. Progress in fit testing of respirators. Chin. J. Nosocomiology 2021, 31, 3836–3840. [Google Scholar]
- Nakamura, M.; Yoda, T.; Crawshaw, L.I.; Kasuga, M.; Uchida, Y.; Tokizawa, K.; Nagashima, K.; Kanosue, K. Relative importance of different surface regions for thermal comfort in humans. Eur. J. Appl. Physiol. 2013, 113, 63–76. [Google Scholar] [CrossRef] [PubMed]
- Scarano, A.; Inchingolo, F.; Lorusso, F. Facial skin temperature and discomfort when wearing protective face masks: Thermal infrared imaging evaluation and hands moving the mask. Int. J. Environ. Res. Public Health 2020, 17, 4624. [Google Scholar] [CrossRef]
- Foo, C.C.I.; Goon, A.T.J.; Leow, Y.-H.; Goh, C.-L. Adverse skin reactions to personal protective equipment against severe acute respiratory syndrome—A descriptive study in Singapore. Contact Dermat. 2006, 55, 291–294. [Google Scholar] [CrossRef] [PubMed]
- Zuo, Y.; Hua, W.; Luo, Y.; Li, L. Skin reactions of N95 masks and medial masks among health-care personnel: A self-report questionnaire survey in China. Contact Dermat. 2020, 83, 145–147. [Google Scholar] [CrossRef] [PubMed]
- Szepietowski, J.C.; Matusiak, Ł.; Szepietowska, M.; Krajewski, P.K.; Bialynicki-Birula, R. Face mask-induced itch: A self-questionnaire study of 2315 responders during the COVID-19 pandemic. Acta Derm. Venereol. 2020, 100, adv00152. [Google Scholar] [CrossRef] [PubMed]
- Carpagnano, G.E.; Lacedonia, D.; Spanevello, A.; Cotugno, G.; Saliani, V.; Martinelli, D.; Foschino-Barbaro, M.P. Is the exhaled breath temperature in lung cancer influenced by airways neoangiogenesis or by inflammation? Med. Oncol. 2015, 32, 237. [Google Scholar] [CrossRef] [PubMed]
- Cherrie, J.W.; Wang, S.; Mueller, W.; Wendelboe-Nelson, C.; Loh, M. In-mask temperature and humidity can validate respirator wear-time and indicate lung health status. J. Expo. Sci. Environ. Epidemiol. 2019, 29, 578–583. [Google Scholar] [CrossRef] [PubMed]
- Yilma, K.T.; Limeneh, D.Y. Review on moisture management finish: Mechanism and evaluation. J. Nat. Fibers 2021. [Google Scholar] [CrossRef]
- Roberge, R.J.; Kim, J.-H.; Benson, S. N95 filtering facepiece respirator deadspace temperature and humidity. J. Occup. Environ. Hyg. 2012, 9, 166–171. [Google Scholar] [CrossRef]
- Lee, K.-P.; Yip, J.; Kan, C.-W.; Chiou, J.-C.; Yung, K.-F. Reusable face masks as alternative for disposable medical masks: Factors that affect their wear-comfort. Int. J. Environ. Res. Public Health 2020, 17, 6623. [Google Scholar] [CrossRef]

| Number | Sample Name | Product Type | Manufacturer | Material | Code |
|---|---|---|---|---|---|
| 1 | Surgical Face Mask | Surgical mask | Tiger Medical Products Ltd. (Shanghai, China) | Polypropylene | SM |
| 2 | Healthcare Particulate Respirator | Medical respirator | 3M (St. Paul, MN, USA) | Polypropylene | PM |
| Time | SM | PM |
|---|---|---|
| 0 h | No penetration | No penetration |
| 2 h | No penetration | No penetration |
| 4 h | No penetration | No penetration |
| 6 h | No penetration | No penetration |
| 8 h | No penetration | No penetration |
Publisher’s Note: MDPI stays neutral with regard to jurisdictional claims in published maps and institutional affiliations. |
© 2022 by the authors. Licensee MDPI, Basel, Switzerland. This article is an open access article distributed under the terms and conditions of the Creative Commons Attribution (CC BY) license (https://creativecommons.org/licenses/by/4.0/).
Share and Cite
Guan, X.; Lin, J.; Han, J.; Gao, X.; Zhang, Y.; Hu, B.; Guidoin, R.; Wang, L. Prolonged Use of Surgical Masks and Respirators Affects the Protection and Comfort for Healthcare Workers. Materials 2022, 15, 7918. https://doi.org/10.3390/ma15227918
Guan X, Lin J, Han J, Gao X, Zhang Y, Hu B, Guidoin R, Wang L. Prolonged Use of Surgical Masks and Respirators Affects the Protection and Comfort for Healthcare Workers. Materials. 2022; 15(22):7918. https://doi.org/10.3390/ma15227918
Chicago/Turabian StyleGuan, Xiaoning, Jing Lin, Jiaxiang Han, Xiaodong Gao, Ying Zhang, Bijie Hu, Robert Guidoin, and Lu Wang. 2022. "Prolonged Use of Surgical Masks and Respirators Affects the Protection and Comfort for Healthcare Workers" Materials 15, no. 22: 7918. https://doi.org/10.3390/ma15227918
APA StyleGuan, X., Lin, J., Han, J., Gao, X., Zhang, Y., Hu, B., Guidoin, R., & Wang, L. (2022). Prolonged Use of Surgical Masks and Respirators Affects the Protection and Comfort for Healthcare Workers. Materials, 15(22), 7918. https://doi.org/10.3390/ma15227918

